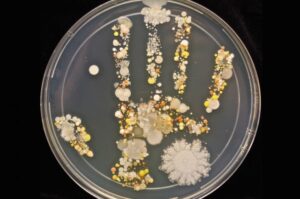

I ricercatori hanno scoperto che i bambini obesi possiedono una popolazione di microrganismi viventi nel loro tratto intestinale diversa da quella dei bambini più magri. Secondo i ricercatori, questi microrganismi sembrano accelerare le reazioni di conversione dei carboidrati in grassi che si accumulano in tutto il corpo.
Lo studio è il primo a ricercare un collegamento tra la flora intestinale e la distribuzione della massa grassa nei bambini. I microrganismi intestinali nei bambini obesi sono simili a quelli osservati nei precedenti studi sugli adulti obesi confermando l’evidenza che i batteri giocano un ruolo importante sull’aumento di peso in eccesso fin dalla più tenera età.
I ricercatori non sono in grado di determinare il perché i microrganismi differiscono tra le persone magre e quelle grasse, ma hanno ipotizzato che la diversa dieta contribuisce alla crescita di un tipo di batteri rispetto ad un altro.
Secondo questi studi, condotti dal Dr. Nicola Santoro, uno scienziato ricercatore nel dipartimento di pediatria dell’Universita Yale nel New Haven (Connecticut), una dieta ricca di carboidrati può favorire la crescita dei batteri fermentantanti e favorire l’accumulo dell’energia in più sotto forma di grasso corporeo.
La fermentazione è un processo in cui i batteri intestinali metabolizzano i carboidrati e li convertono in altri composti, inclusi i grassi.
In Italia, circa il 15 % dei bambini ed adolescenti sono obesi, una percentuale 4 volte maggiore rispetto a quella di 30 anni fa. I bambini obesi sono sempre più propensi a diventare adulti obesi e ad avere seri rischi di salute a livello cardiovascolare e metabolico. Secondo i Centri per il Controllo e la Prevenzione delle Malattie, gli obesi sono ad alto rischio di problemi cardiaci, diabete di tipo 2, ictus, diversi tipi di tumori e osteoartriti.
Negli studi guidati da Santoro e pubblicati il 20/09/2016 nel Journal of Clinical Endocrinology & Metabolism, i ricercatori hanno esaminato i microrganismi intestinali di 84 bambini e adolescenti dai 7 ai 19 anni. Di questi, 27 obesi, 35 gravemente obesi, 7 in sovrappeso e 15 di normopeso. I partecipanti sono anche stati sottoposti a risonanza magnetica per misurare la distribuzione del grasso corporeo.
I ricercatori hanno identificato otto gruppi, o phylum, di microrganismi intestinali che sono stati associati alla fermentazione dei carboidrati e all’accumulo di grassi, Quattro di questi phylum prosperavano nei bambini obesi, specialmente nei più obesi. Anche piccole quantità degli altri quattro gruppi di microrganismi sono state trovate nei partecipanti obesi. Questi batteri erano assenti o presenti solo in piccole quantità nelle persone magre.
In generale, la flora intestinale trovata nei bambini obesi risultava essere più efficiente nella conversione dei carboidrati in grassi rispetto alla normale flora presente negli individui normopeso. Ciò suggerisce come, anche a parità di apporto calorico, i giovani obesi accumulano più grassi rispetto alle persone magre a causa della diversa composizione della flora intestinale.
Quindi in futuro, delle modifiche alla composizione delle specie microbiche della flora intestinale, potrebbero aiutare a prevenire o trattare l’obesità prima del suo esordio.
Oltre al cambiamento della dieta, che potrebbe alterare la flora intestinale, alcuni ricercatori stanno considerando il trapianto fecale come possibile tecnica per poter modificare la composizione delle specie microbiche intestinali. Ciò comporterebbe l’ingurgito di pillole di feci liofilizzate di persone magre, con la speranza di trapiantare una popolazione batterica diversa, batteri che favoriscono di meno l’accumulo di grasso.
Alcuni ricercatori stanno adesso reclutando dei partecipanti per condurre il primo studio sul trapianto fecale nei bambini. Questo studierà l’uso dei trapianti per il trattamento della malattia infiammatoria intestinale, che è fortemente associata sia con l’obesità che con il tipo di flora intestinale.
Fonte: LiveScience.